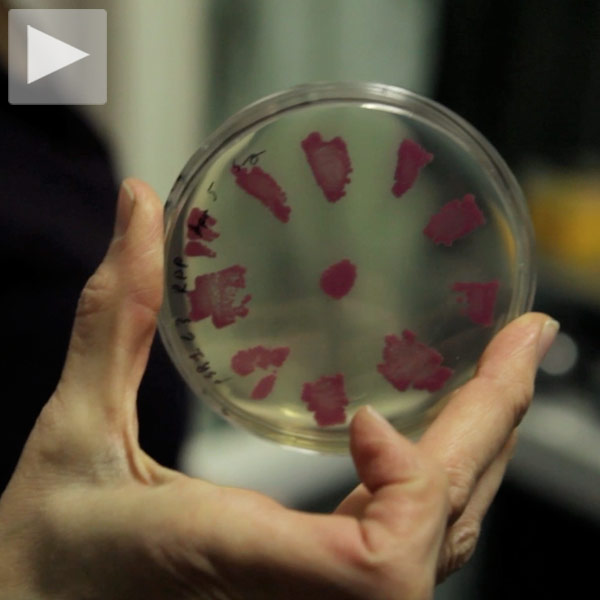
genspace-th1-96506

How Origami Is Innovating Technology

Origami dates back to the 17th century in Japan, but it wasn’t until the mid-20th century that people began to consider the practice an art form due, in large part, to origami …
Find all stories on Biotechnology in this tag archive.

Origami dates back to the 17th century in Japan, but it wasn’t until the mid-20th century that people began to consider the practice an art form due, in large part, to origami …

There are several types of plastic in a single-use face mask, and they don’t easily decompose—instead winding up in the ocean. In fact, one face mask can release up to 173,000 microfibers …

Founded by MIT scientists, the clinical-stage biotech company Frequency Therapeutics discovered a way to reverse hearing loss without hearing aids or implants. Focusing on progenitor cells (which reside in the inner ear …

At the annual event we found health-improving tech, mobility-driven innovation and everything between
Brooklyn's community biotech lab, a place for experimentation and learning